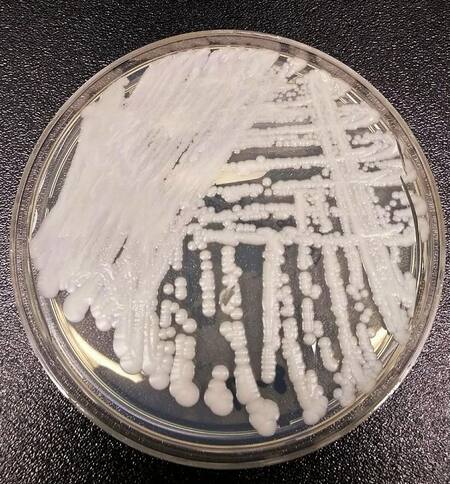
Cnadida auris. Foto: Wikipedia

Detectaron dos casos en la Argentina del peligroso hongo Candida auris
Según expertos, el hongo puede persistir en los hospitales por semanas.

El ministerio de Salud afirmó que encontraron en la Argentina dos primeros casos de Candida auris, una especie de hongo que crece como la levadura, "provenientes de muestras de pacientes tratados en una clínica de la Ciudad Autónoma de Buenos Aires".
El Instituto Nacional de Enfermedades Infecciosas INEI-ANLIS “Dr. Carlos G. Malbrán” informó a la dirección de Epidemiología sobre los dos aislamientos, Según el Boletín Epidemiológico Nacional (BEN).
También se le infirmó a la gerencia Operativa de Epidemiología del ministerio de Salud de la Ciudad Autónoma de Buenos Aires (CABA), y se llevó a cabo una reunión entre las autoridades y médicos de la clínica, equipo del ministerio de la ciudad y equipos técnicos porteños.
"Al momento, se encuentran en proceso técnicas moleculares para caracterizar el patógeno y pruebas de sensibilidad in vitro con el método de referencia", informó el Boletín Epidemiológico Nacional.
Candida auris. Foto: Wikipedia.
Información sobre los casos de Candida auris detectados
Uno de los pacientes aislados está internado desde el 2 de octubre en la unidad de cuidados intensivos en una clínica de CABA, que fue derivado de una clínica del exterior mediante un vuelo sanitario.
El día 18 de octubre se le realizó un urocultivo con aislamiento de Candida sp, y el resultado, diez días después, se identificó como Candida auris.
La otra persona aislada “presenta una fístula de drenaje posquirúrgica y es tratado de forma ambulatoria en la misma clínica”.
Los dos pacientes “no compartieron el mismo ámbito en el mismo momento durante su estadía en la clínica y la investigación epidemiológica continúa en proceso”, afirmó el Boletín.
Ricardo Teijeiro (M.N. 58.065), es infectólogo y dijo que el hongo está mayormente en geriátricos y hospitales, contaminando a personas que no tengan ninguna patología.
"La infección puede ser riesgosa para aquellos pacientes con problema de inmunosupresión u oncológicos, cuyos perjuicios pueden provocar la muerte del infectado", señaló el médico.
Remarcó que esta enfermedad tiene mucha resistencia porque no evoluciona bien con antimicóticos comunes y no es fácil de curarlo como otros hongos que afectan a las personas.
Para prevenir la mutación del hongo, según Ricardo Teijeiro, la mejor forma es limpiar e higienizar constantemente los sitios donde se encuentran pacientes inmunodeprimidos y realizar el tratamiento correcto para la persona que lo tenga.
El especialista remarcó que el contagio es entre "personas con problemas inmunológicos" y que en aquellos pacientes que no tienen problemas de salud "no produce enfermedades graves".

¿De qué se trata la Cándida auris?
Ángel Colque (M.N.13.854), infectólogo de la Sociedad Argentina de Infectología, informó que esta patología se trata de un hongo que produce infecciones invasivas y brotes hospitalarios.
"La mayoría de las infecciones se observan en pacientes crónicamente enfermos con estadías prolongadas y alto requerimiento de los servicios de salud", comentó.
También afirmó que: “Se debe considerar como brote y tomar las medidas necesarias para contenerlo, llevadas a cabo por el laboratorio de microbiología y los comités de control de infecciones de cada institución”.
El objetivo es el control de los brotes, que incluye “la rápida identificación de la C. auris en pacientes hospitalizados, que es particularmente importante para que las instituciones puedan tomar precauciones especiales para detener su propagación”, explicó el infectólogo.
La emergencia de este hongo “se debe a su facilidad para persistir y causar brotes en el ámbito hospitalario, así como a la escasa eficacia de los antifúngicos para controlar la infección”, repasó el informe.

















